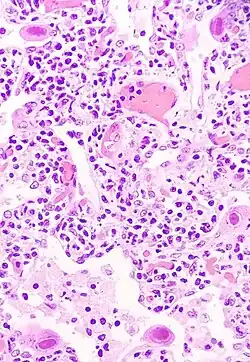
Image illustrative de l’article Cytomégalovirus, journal d'hospitalisation

Cytomégalovirus, journal d'hospitalisation
| Cytomégalovirus, journal d'hospitalisation | ||||||||
Pneumocytes infectés par le cytomégalovirus | ||||||||
| Auteur | Hervé Guibert | |||||||
|---|---|---|---|---|---|---|---|---|
| Pays | France | |||||||
| Genre | Journal intime | |||||||
| Éditeur | Éditions du Seuil | |||||||
| Date de parution | 1992 | |||||||
| Type de média | Livre | |||||||
| Nombre de pages | 92 | |||||||
| ISBN | 2-02-014727-0 | |||||||
| Chronologie | ||||||||
| ||||||||
Cytomégalovirus, journal d’hospitalisation est une œuvre d’Hervé Guibert publiée à titre posthume en 1992 aux Éditions du Seuil. Du au , l’auteur, atteint du sida, est hospitalisé. Il risque de perdre la vue à la suite d'une infection au cytomégalovirus. Il rédige ce journal quelques mois avant de mourir, le .
Commentaires
Il s’agit d’un texte court, chargé à la fois d’émotion et de cruauté. L’univers hospitalier y est décrit sans complaisance. Au travers des exigences formulées auprès du personnel soignant, se devine la volonté de l’auteur de mourir dignement. Ses amis l’entourent et le préparent à la mort : dernières volontés, enterrement, séparation des êtres aimés. Hervé Guibert évoque aussi son travail d’écriture et photographique.
Citations
« Ce matin, j’ai essayé de chercher dans le ciel voilé des aquarelles de Turner ou de Constable. Il y en avait parfois. »
« L’après-midi se traîne. Vivement la nuit, l’oubli. »
« Ecrire dans le noir ? Ecrire jusqu’au bout ? En finir pour ne pas arriver à la peur de la mort ? »
Annexes
Bibliographie
- Bruno Blanckeman, Les récits indécidables. Jean Echenoz, Hervé Guibert, Pascal Quignard, Villeneuve-d'Ascq, Presses Universitaires du Septentrion, , 224 p. (ISBN 978-2-7574-0010-4, présentation en ligne)
- Stéphane Spoiden, La littérature et le SIDA: archéologie des représentations d'une maladie, Toulouse, Presses Universitaires du Mirail, , 232 p. (ISBN 2-85816-578-5)
- Arnaud Genon, Roman, journal, autofiction : Hervé Guibert en ses genres, Paris, Mon petit éditeur, , 108 p. (ISBN 2342028393)
Articles connexes
Liens externes
- Portail de la littérature française
- Portail de la médecine
- Portail des années 1990
- Portail LGBT+